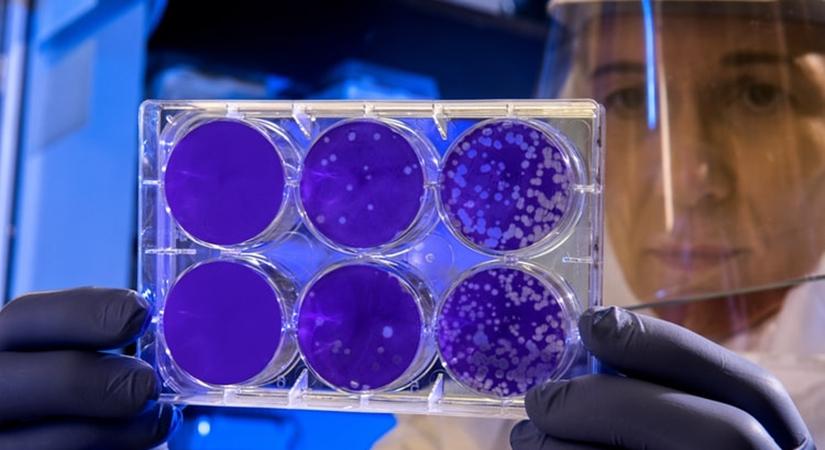
Rare Disease Day: Are they are common than you think?

Cover Story
World Rare Disease Day: Are they more common than you think?
A rare disease, also known as 'orphan disease' is said to affect a small percentage of the population, and are difficult to diagnose
ByIANSlife Features
February 29, 2020 (IANSlife) World Rare Disease Day is observed every year on the last day of February.
A Rare Disease is also known as Orphan Disease and is said to affect a small percentage of the population. It presents a countless number of challenges for patients and their family members, including the time it takes to obtain a correct diagnosis.
Although cancer and heart disease get plenty of media attention, the impact and reach of rare diseases vary significantly. One of the rare diseases may affect only a handful of patients, while another disease could affect many. At times, Rare Diseases are difficult to diagnose because of its nonspecific symptoms and because they’re so unusual.
It is said that 1 in 20 Indians is affected by a Rare Disease. According to Indian Society for Clinical Research (ISCR). 70 million in India and 350 million people around the world suffer from rare diseases.
There are more than 7,000 distinct types of Rare and Genetic diseases and it has impacted more people than Cancer and AIDS combined and most of which are progressive, life-threatening, and chronically debilitating conditions and 80 percent of these rare diseases have a genetic origin.
Dr. Mayuri.K.S., Consultant Microbiologist and Infection Control Officer, SPARSH Hospital, Bengaluru shares few types of rare diseases:

Acanthamoeba keratitis
Acanthamoeba keratitis is a vision-threatening rare disease which causes parasitic infection and can be seen most often in contact lens wearers. It is found ubiquitously in soil and water and can cause infections of the skin, eyes, and central nervous system.
This infection of the cornea is difficult to treat with conventional medications. It may lead to permanent visual impairment and blindness in some cases because of damage to the clear portion of the front of the eye called the cornea or through damage to other structures important to one’s vision.
Creutzfeldt–Jakob disease (CJD)
Creutzfeldt–Jakob disease is also known as Classic Creutzfeldt–Jakob disease. CJD is a fatal degenerative brain disorder which is believed to be caused by a protein known as prions. The early symptoms include visual disturbances, memory problems, behavioural changes and also poor coordination.
The later symptoms include weakness, involuntary movements, blindness, dementia and coma. About 70 percent of people die within a year of diagnosis as there is no specific treatment for CJD.
Cysticercosis
Cysticercosis is a rare infectious disease. It is a tissue infection which is caused by the tapeworm present in the pork. It is known to cause neurocysticercosis which affects the brain and can cause neurological symptoms. Individuals suffering from this rare disease may have few or no symptoms for years.
Cysticercosis is usually acquired by eating contaminated food. One of the major sources is said to be uncooked vegetables. Drinking water contaminated by tapeworm eggs from human feces is also one of the main reasons to cause the infection.
Mucormycosis
Mucormycosis is caused by fungi in the order Mucorales. And they are generally the species in the Mucor, Rhizopus, Absidia and Cunninghamella. The disease is often characterized by hyphae growing in and around blood vessels and can be potentially life-threatening in diabetic or severely immune-compromised individuals.
Mucormycosis and zygomycosis are sometimes used interchangeably. It frequently infects the sinuses and the brain. While infection of the oral cavity or brain is the most common form of mucormycosis and it enters the body through a cut in the skin. The fungus can also infect other body areas such as the gastrointestinal tract, other organ systems and in rare cases, the maxilla may be affected by mucormycosis.
Fungal infections are usually prevented by the rich blood vessel supply of maxillofacial areas. Although more virulent fungi responsible for mucormycosis can often overcome this difficulty.
Naegleriasis
It is also known as PAM - Primary Amoebic Meningoencephalitis. This rare disease is an almost invariably fatal infection of the brain by the free-living unicellular eukaryote Naegleria fowleri. Symptoms are meningitis which includes headache, fever, nausea, vomiting, a stiff neck, confusion, hallucinations and seizures. Symptoms progress rapidly over five days and death usually results within one-to-two weeks of symptoms.
Nocardiosis
Nocardiosis is an infectious disease affecting either systemic nocardiosis which is the whole body or pulmonary nocardiosis which are the human lungs. It is caused due to an infection by a bacterium of the genus Nocardia, most commonly Nocardia asteroides or Nocardia brasiliensis. It is most commonly seen in adult males, especially those with a weak immune system.
Patients with brain Nocardia infection, mortality exceeds 80%, in other forms, mortality is 50%, even with appropriate therapy. It is one of several conditions that have been called "the great imitator" and Cutaneous nocardiosis commonly occurs in immunocompetent hosts.
Rat-bite fever
It is an acute, febrile human illness caused by bacteria transmitted by rodents, in most cases, which is passed from rodent to humans by the rodent's urine or mucous secretions. Alternative names for this rare disease include streptobacillary fever, streptobacillosis, spirillary fever, bogger, and epidemic arthritic erythema. It is spread by infected rodents and can be caused by two specific types of bacteria.
In some of the cases are patients were diagnosed after they were exposed to the urine or bodily secretions of an infected animal. These secretions can come from the various body parts like mouth, nose or eyes of the rodent and majority of cases are due to the animal's bite. It is also said to be transmitted through food or water contaminated with rat feces or urine.
Other animals that can be infected with this disease are household pets, weasels, gerbils and squirrels. It is important to quickly wash and cleanse the wound area thoroughly with an antiseptic solution to reduce the risk if a person is bitten by a rodent.
Cat-scratch disease (CSD)
It is caused due to scratching or biting of a cat. Typically include a non-painful bump or blister at the site of injury caused due to scratch or bite. Within 3-14 days following infection and the individual may feel tired, have a fever and headache.
Cat scratch disease is caused by the bacterium Bartonella henselae spread by the cat's saliva. Young cats pose a greater risk than older cats. Diagnosis is generally based on symptoms but confirmed through blood tests.
The primary treatment is supportive. Recovery occurs within four months but can require a year. About 1 in 10,000 people are affected and it is found to be more common in children. These diseases may seem to be rare, but there is a significant figure that highlights just how many people are living with it but that gets a little attention due to their singularity. The challenges they face are common to millions of people across the world.
There is much work to be done to spread the awareness of rare diseases and also to improve the diagnosis and treatment of rare diseases. Only less than 5 percent of the 7000 rare diseases have approved therapies. On average, the rare disease patient waits about five years from symptom onset to accurate diagnosis.
In order to tackle the challenges that people living with a rare disease and their families face every day, awareness campaigns should focus on bridging all the gaps in the coordination between medical, social and support services.
(This article is a website exclusive and cannot be reproduced without the permission of IANSlife)
IANSlife can be contacted at ianslife@ians.in
Editing by Aditi Roy and N. Lothungbeni Humtsoe


